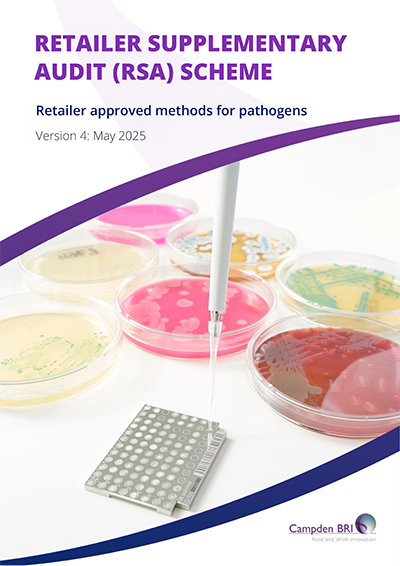

Retailer supplementary audit (RSA) scheme
To discuss your needs
Overview
- Independent audit required by M&S/Tesco for any Microbiology Laboratory to undertake pathogen tests on “own label” products and associated materials
- Replaces M&S ISA and Tesco TLAS Initiatives
- Supplementary audit, independent of laboratories ISO/IEC17025:2017 accreditation
- Requires compliance with specific retailer requirements for management, control and reporting of work
- Requires use of approved methods
- Promotes effective co-operation between M&S/Tesco Suppliers and Laboratories
- RSA Compliance for defined scope of pathogen tests with performance level assigned
The RSA scheme drives delivery of consistent, accurate, reliable, defendable and timely results for the benefit of retailers and their suppliers.
More about the Scheme
Scheme documents (only available to scheme members)
Campden BRI RSA Scheme for M&S and Tesco
For product safety M&S, Tesco and their Suppliers must have confidence in pathogen results to ensure action is taken based on reliable data.
The Campden BRI Retailer Supplementary Audit (RSA) Scheme was established with M&S and Tesco and launched in 2019 to provide common supplementary audit scheme for both Retailers to recognise Microbiology Laboratories that undertake pathogen tests on their own label products and related materials
Audits are specific to M&S/Tesco pathogen testing activities to verify if standard of service, quality of work and reliability of results meets Retailer specific requirements and methods comply with Retailer approved methods.
A performance related approach is used to appraise ability to deliver consistent, accurate, reliable, defendable and timely pathogen results.
RSA Compliance status requires successful completion of an annual audit and a performance level is given based on audit findings.
Scope of RSA audits
Food, drink, components and environmental swabs where M&S or Tesco has set microbiological criteria for one or more of the following pathogens:
- Salmonella spp;
- Listeria monocytogenes and Listeria spp;
- Campylobacter spp;
- E.coli O157/STEC
- Cronobacter spp
- Vibrio parahaemolyticus, Vibrio cholerae, Vibrio vulnificus
- Bacillus cereus
- Clostridium perfringens
- Coagulase positive Staphylococci
RSA Scopes of Compliance will cover only pathogens and methods actively used to test M&S/Tesco materials that meet Retailer requirements. Extensions/modifications can be made between audits or at annual audits to keep Scopes relevant to laboratories needs.
RSA Scheme documents
On registration with the RSA Scheme laboratories will be given access to:
- RSA Scheme Protocol - conditions for participation, audit process and validity of RSA Compliance
- Retailer Requirements for Microbiology Laboratories Performing Pathogen Tests - activities covered by audits and requirements laboratories must meet.
- Retailer Approved Methods for Pathogens - approved methods that must be used for M&S and Tesco materials.
Retailer requirements for laboratories
Retailer requirements for laboratory operations, management, delivery of work, and result reporting include enhancements to requirements in ISO/IEC 17025 and specific retailer requirements not covered by ISO/IEC 17025 based assessments including areas where concerns could impact on results.
No RSA requirements conflict with or contravene ISO/IEC 17025:2017.
Retailer approved methods
To promote reliable results and strengthen due diligence in relation to food safety only methods of recognised status, fully supported by robust validation and compatible with requirements in relevant legislation for pathogens are approved for use by M&S and Tesco.
Use of RSA Retailer approved methods only applies to pathogen testing performed on M&S/Tesco materials. There is no requirement for laboratories to use these methods for other client work.
Requests for approval to use an alternative to an RSA Retailer approved method can be considered by the RSA Scheme Method Review Coordinator and Retailers. If approved the method will be added to the list of RSA Retailer approved methods. (This process is outlined in the RSA Protocol)
M&S/Tesco supplier responsibilities
Effective communication and provision of information between M&S/Tesco Suppliers and laboratories is essential to ensure retailer requirements and responsibilities for sample submission, testing and reporting are clearly understood, agreed by both parties and followed.
Co-operation is necessary between Suppliers and laboratories for laboratories to demonstrate compliance with relevant Retailer requirements.
General guidance notes for Supplier input/responsibilities will be available soon.
RSA Compliant laboratories
RSA Compliant laboratories and RSA status
Eligibility to join RSA scheme
Any microbiology laboratory that satisfies the following can register to be an RSA Compliant laboratory:
- Must have an M&S/Tesco Supplier as customer (or can demonstrate a Suppliers commitment as a new customer to use the laboratory).
- Must test M&S/Tesco food, drink, components and/or environmental swabs for 1 or more of the following pathogens: Listeria, Salmonella, Campylobacter, E.coli O1576/STEC, Cronobacter, Vibrio, Staphylococcus aureus, Bacillus cereus, and Clostridium perfringens.
- Must be accredited to an ISO17025 based standard by a recognised Accreditation Body (e.g. UKAS, INAB or International Equivalent, CLAS) for the pathogen testing activities in question.
Application for RSA compliance
New applications: Please complete and return the RSA Scheme application form
Please note the requirements in this form relating to Data Processing and Disclosure of Information on this RSA webpage and to M&S/Tesco concerning participation in the RSA Scheme and your laboratory’s acceptance of these.
An audit approx. 3 months after receipt of application will normally be offered. (To allow review of RSA requirements and methods, and make changes to comply). Thereafter subsequent audits will be in the due month. If needed, Provisional RSA Compliance can be considered upon to ensure Retailer work is in place for the audit. (Applicable only to new applications – see RSA Protocol for details).
Requests for Extensions/Modifications to RSA Scopes In between Audits: Please complete and return the RSA Extension to Scope form
Key services
HACCP in manufacturing
Our HACCP products and services are based on extensive experience helping with the development and implementation of HACCP–based systems.
CLAS (Campden Laboratory Approval Scheme)
Leading scheme for laboratories. Established specifically to meet the need for a recognised standard for food, drink and allied laboratories.
Retailer supplementary audit (RSA) scheme
Drives delivery of consistent, accurate, reliable, defendable and timely results for the benefit of retailers and their suppliers.
Culture excellence
The Culture Excellence Program is a unique solution for the measurement, analysis and improvement of safety and quality culture.
Microbiology training courses
Explore our microbiology related courses including; Understanding microbiology for non microbiologists and Setting shelf life: how to do it better
Are you getting the most from your Membership?
Watch our membership FAQ videos and find out more about Member Service Account spending, Member Interest Groups, help and advice
Where we refer to UKAS Accreditation
The Campden BRI group companies listed below are accredited in accordance with the recognised International Standard ISO17025:2017 by the United Kingdom Accreditation Service (UKAS). The accreditation demonstrates technical competence for a defined scope of methods, specific to each site, as detailed in the schedules of accreditation bearing the testing laboratory number. The schedules may be revised from time to time and reissued by UKAS. The most recent issue of the schedules are available from the UKAS website www.ukas.com. Campden BRI (Chipping Campden) Limited is a UKAS accredited testing laboratory No. 1079